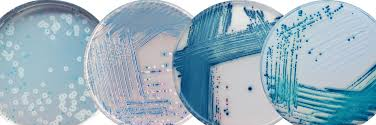
Simon Cameron banner

Simon Cameron retweetledi

Just over a week to apply to my PhD project to help develop some new software tools for mass spectrometry data analysis. #TeamMassSpec
findaphd.com/phds/project/b…

English
Simon Cameron
61 posts

@SJS_Cameron
Senior Lecturer at @QUBbioscience and @qubigfs at Queen's University Belfast. Research in microbiology, mass spectrometry, and human milk. My views.































